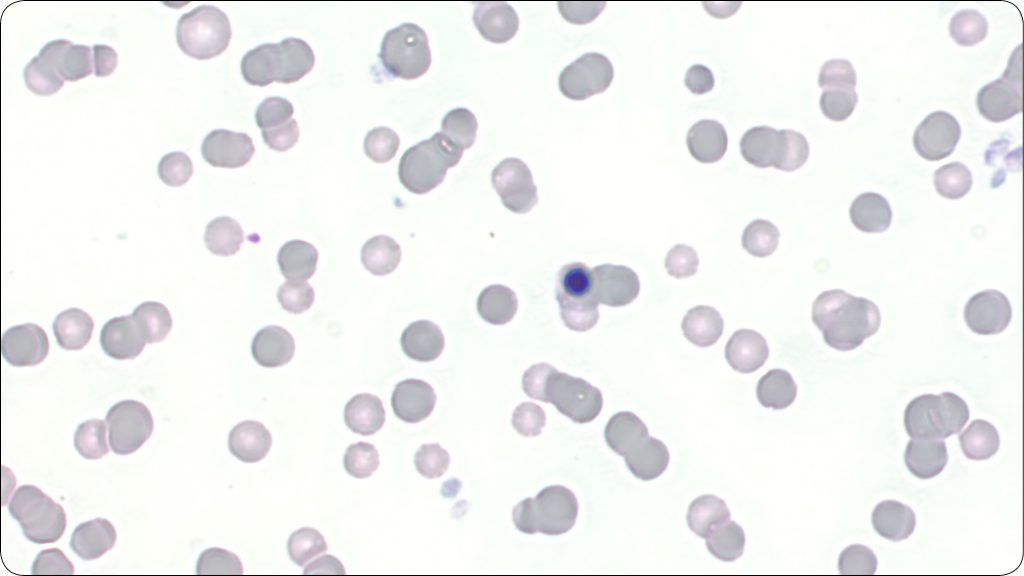
KONIE_24_Marzena_Paszkowska_KIEDY_WARTO_ZLECIC_ROZMAZ_KRWI_U_KONI_RYC_3

Kiedy warto zlecić rozmaz krwi u koni?
Po drugie, w rozmazie możliwe jest postawienie podejrzenia aglutynacji erytrocytów, sugerującej immunohemolityczne tło niedokrwistości – IMHA (ryc. 3). Weryfikacja występowania aglutynacji następuje w teście aglutynacji szkiełkowej. Niedokrwistości immunohemolitycznej może także towarzyszyć obecność sferocytów (choć rzadko spotykana u koni). W przypadku hemolizy na tle uszkodzeń oksydacyjnych erytrocytów (np. w przypadku zatruć liśćmi czerwonego klonu lub DMSO) w rozmazie można odnotować natomiast obecność ciałek Heinza i ekscentrocytów (3). Uszkodzenia oksydacyjne erytrocytów są również możliwe na innym tle – np. w przypadku silnych stanów zapalnych – zwykle jednak są one łagodniej wyrażone i nie prowadzą do rozwoju anemii.
W odróżnieniu od małych zwierząt, wyraźne zmiany charakterystyczne dla długotrwałego niedoboru żelaza – niedobarwliwość erytrocytów, obecność mikrocytów czy poikilocytoza – są raczej rzadkie u koni (tab. 1).

Zmiany w układzie białokrwinkowym
Wśród powodów, dla których warto wykonać rozmaz krwi u koni, należy wymienić: weryfikację leukogramu z oznaczenia maszynowego, ocenę cech pobudzenia komórek oraz identyfikację komórek atypowych.
Pierwsza z tych przyczyn wynika z faktu, że [...]
którzy są subskrybentami naszego portalu.
i ciesz się dostępem do bazy merytorycznej wiedzy!
POSTĘPOWANIA
w weterynarii




